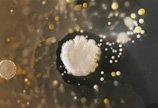
亲眼看一看手机上的细菌

-
 眼中的寄生虫
眼中的寄生虫 -
亲眼看一看手机上的细菌
亲眼看一看手机上的细菌 -
 危险之美:显微镜下病毒彩显图
危险之美:显微镜下病毒彩显图 -
 水百合 凉血消肿
水百合 凉血消肿 -
 面部移植手术图解
面部移植手术图解 -
 男性人体经络穴位图背面
男性人体经络穴位图背面 -
 中医图解指趾再植手术
中医图解指趾再植手术 -
 脑室腹腔引流手术
脑室腹腔引流手术 -
 眼角膜移植手术图解
眼角膜移植手术图解 -
 模特人模拟真人分娩实况记录
模特人模拟真人分娩实况记录 -
 带你认识拔罐的器具
带你认识拔罐的器具 -
 女性生殖器系统完全图示详解
女性生殖器系统完全图示详解 -
 中医手诊图
中医手诊图 -
 实拍:开颅手术全过程
实拍:开颅手术全过程 -
 中医道具
中医道具 -
 人体全身骨骼图
人体全身骨骼图 -
 内痔切除术全过程
内痔切除术全过程 -
 人体正面解剖图
人体正面解剖图 -
 人体右侧面解剖图
人体右侧面解剖图 -
 高清晰人体头部模型图片
高清晰人体头部模型图片 -
 实拍港姐整容手术全程
实拍港姐整容手术全程 -
 震惊全球的移植手术
震惊全球的移植手术 -
 女人体经络穴位图侧面观
女人体经络穴位图侧面观 -
 女人体经络穴位图背面观
女人体经络穴位图背面观 -
 胸腹连体女婴成功分身
胸腹连体女婴成功分身 -
 图示不同乳房的哺乳技巧
图示不同乳房的哺乳技巧 -
 女性生殖器官医学切片
女性生殖器官医学切片 -
 临床实践护士练习女性导尿
临床实践护士练习女性导尿 -
 国外课堂上的私处检查全程
国外课堂上的私处检查全程
